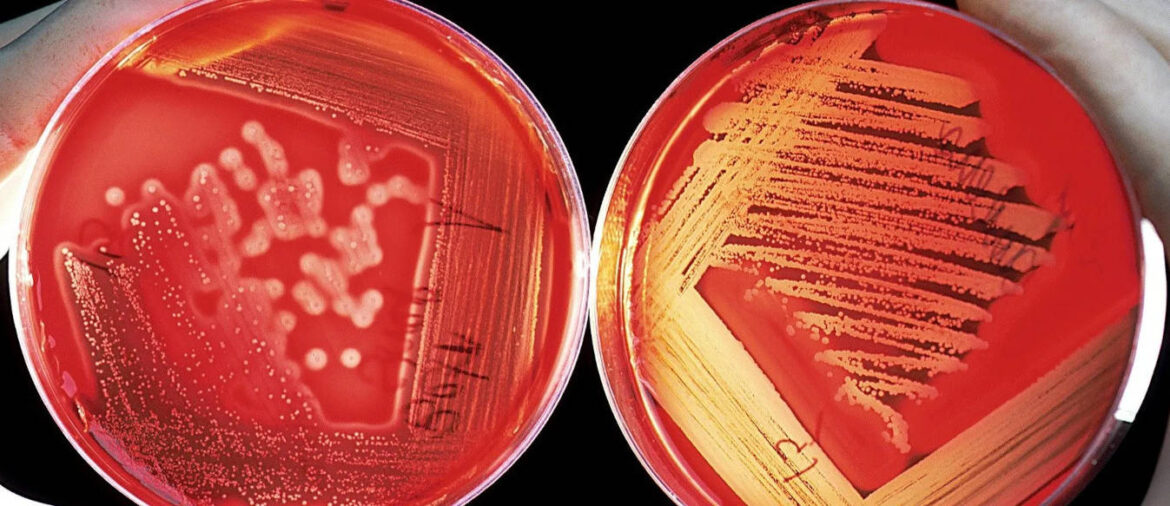
Frotiu sânge

Metalele grele sunt contaminanți ai mediului care pot rezulta din diferite activități umane și pot interfera cu accesul la apă potabilă sau la terenuri pentru construirea de locuințe. De exemplu, prevalența apei contaminate cu plumb în Statele Unite ale Americii a arătat consecințele dezastruoase pentru sănătate ale expunerii pe termen lung la acest metal greu.
Recent, oamenii de știință au descoperit o altă consecință majoră asupra sănătății asociată cu expunerea la metale grele: creșterea rezistenței la antibiotice a bacteriilor.
Bacteriile rezistente la antibiotice, cunoscute și sub denumirea de ”superbacterii”, sunt tulpini specifice de bacterii care nu răspund la tratamentul tipic cu antibiotice. Superbacteriile, cum este Staphylococcus aureus rezistent la meticilină (MRSA), au fost responsabile pentru aproape 1,3 milioane de decese în anul 2019 și constituie o problemă din ce în ce mai mare pentru medicină și sănătate.
Majoritatea superbacteriilor au apărut din cauza utilizării necontrolate a antibioticelor, ceea ce a făcut ca bacteriile să-și dezvolte trăsături care să le facă imune față de efectele antibioticelor.
În mod normal, metalele grele sunt toxice pentru speciile de bacterii, însă unele au evoluat pentru a supraviețui prin îndepărtarea ionilor metalici, ceea ce duce și la îndepărtarea medicamentelor antibiotice. Cercetările recente publicate de Universitatea din Wisconsin, S.U.A., descoperă o legătură între expunerea la metale grele și ratele crescute de bacterii rezistente la antibiotice în corpul uman.
Utilizând mostre de la aproape 700 de participanți la un studiu de sănătate desfășurat între 2016 și 2017, cercetătorii au descoperit că nivelurile ridicate de plumb în urină au fost asociate cu un număr mai mare de bacterii rezistente la antibiotice, după ce au luat în considerare alți factori de rezistență. Oamenii de știință au mai descoperit că nivelurile de plumb, dar și nivelurile de bacterii rezistente la antibiotice, au fost mai mari la rezidenții urbani și la populațiile minoritare.
Căile și mecanismele care conduc la rezistența la antibiotice sunt încă în curs de investigare, dar legăturile epidemiologice au stârnit îngrijorare în rândurile autorităților de sănătate publică și ale activiștilor de mediu. Minimizarea expunerii la plumb și alte metale grele nu este importantă doar în lupta împotriva efectelor cronice asupra sănătății, dar va încetini și dezvoltarea speciilor de bacterii rezistente la antibiotice.